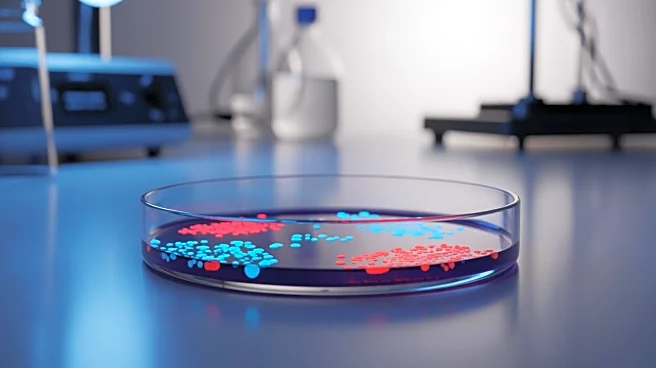
Scientists Warn of Antimicrobial Resistance Becoming Deadlier Than Cancer by 2050

Atlético Madrid coach Diego Simeone was in a defiant mood as he spoke to the media ahead of the final away game of the Champions League’s league stage in Istanbul against Galatasaray. The 55-year-old insisted that his team were aiming for maximum points in their two remaining fixtures.
“We have to win both games, a draw and a win are not enough,” Simeone stated, with Atlético well-positioned to secure a place in the top eight and avoid another knock-out round if they do so.
“There are some very strong
teams, with many teams, important ones, in this group. To avoid playing another playoff, it’s difficult for everyone because it’s very tight,” he continued. “Others will win, and the demands will be very high to be among the top eight.”
Diego Simeone on lessons learned after the win in Eindhoven
“No two games are the same. At that moment, PSV were in very good form. Galatasaray are a very energetic team and will demand the utmost from us.”
Simeone on what kind of game he expects
“The opposition have some very good players in attack. (Victor) Oshimen is back, they have two wingers in great form, (Ilkay) Gündogan in the middle, who we know is top class… I see a very competitive team, and we will try to take the game where we think we can hurt them.”
Simeone on clinical finishing
“In football, the only way to score goals is to create scoring opportunities. We work to apply this and execute it better and better so that we can do it.”
Simeone on the video of headers for Sørloth
“The truth is that there’s little to teach him because he’s very strong in the air, he helps us a lot with the ball. We need him to be strong.”
Simeone on the transfer window
“There are still a few days left for a new signing to arrive and it will surely happen. Let’s focus on what concerns us, which is the present. We’re thinking about the people who are here.”
Simeone on whether Julián Alvarez will be at his best in a game like this
“Yes.”
Simeone on Johnny Cardoso
“As always, we have personal conversations with the players, and that’s how they are: personal. We show them what we think, what we believe, with an open door for all those who understand Atlético’s style of play.”
Simeone on the previous meeting with Galatasaray in 2015
“The work on their part has been incredible, to be able to sustain this period in the way they have worked to maintain their position. Thinking about that team and today’s team, there are different characteristics because there are different players. The atmosphere, this stadium, I love it. The energy of the city. Of the people. They convey the most beautiful thing about this football, which is passion.”
Simeone on having conceded 12 goals from set pieces, one of Galatasaray’s strengths
“Let’s hope that tomorrow we can resolve that situation in the best possible way, because it’s very important.”
Alexander Sørloth on what’s changed in his form
“It’s a combination. Playing more minutes and the team looking for me. I’m very happy with this streak and I hope it continues.”
Sørloth on the game against Galatasaray
“Yes, it’s important. We want to be in the top eight and go through to the next round directly.”
Sørloth on aerial play
“Sometimes you want to but you can’t, now I have a lot of confidence and my teammates also have confidence in me, and that’s the key word.”
Sørloth on his future
“I’m very happy here, I show it on the field, playing and competing for Atlético.”
Sørloth on being more of a target in attack
“This summer we signed a lot of players and we need time to adapt, to connect, to get those mechanisms in place. Now we’re better. I’m getting into the box more and we’re finding that combination between teammates that makes it easier for me.”
Sørloth on a hostile atmosphere
“I played a season in Turkey, all the stadiums were full. They love football, they enjoy it, and if you enjoy it, this is a place where you enjoy playing. Personally, I really like playing in Turkey because of the atmosphere in the stadiums. Galatasaray has very good players, I can’t talk about any specific ones, but they have a very good team.”
Sørloth on Simeone’s praise of him
“It’s always nice when he speaks highly of me.”